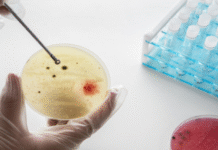
Airborne Pathogens Twice as Prevalent in Crowded Cities, Study Finds

Florida Plans to Eliminate All Vaccine Mandates, Sparking Fierce Backlash
FLORIDA-- Florida announced Wednesday that it plans to eliminate all state vaccine mandates, including those for schoolchildren, becoming the first state in the nation...
Cancer cases highest in women in India, men more at risk of mortality: ICMR...
NEW DELHI-- Women in India reported a higher incidence of cancer than men, but the risk of death was greater among men, according to...
Airborne Pathogens Twice as Prevalent in Crowded Cities, Study Finds
NEW DELHI-- Airborne pathogens that trigger infections in the lungs, gut, mouth, and skin are found at nearly double the levels in densely populated...
Surgery Proves More Effective than Antibiotics in Treating Chronic Sinusitis, Study Finds
New Delhi – A groundbreaking clinical trial has revealed that surgery is more effective than antibiotics in treating chronic sinus disease, also known as chronic...
Schizophrenia, Depression May Nearly Double Risk of Heart Disease and Death: Study
New Delhi-- Mental health conditions such as schizophrenia and depression can significantly increase the risk of heart disease and mortality, in some cases by...
Study Finds Dormant Bacteria Can Trigger Heart Attacks
NEW DELHI-- Heart attacks, or myocardial infarctions, may be triggered not only by cholesterol buildup but also by dormant bacterial infections, according to a...
US Scientists Working on Single-Dose Vaccines for HIV and Covid
NEW DELHI-- Scientists in the United States are developing vaccines that could offer long-lasting protection against HIV, Covid-19, and potentially other infectious diseases with...
Study Finds No Strong Evidence That Acupuncture, Music Therapy Help Autism
NEW DELHI-- Complementary and alternative treatments such as acupuncture and music therapy show no strong evidence of effectiveness in treating autism, according to a...
Study Finds Ibuprofen, Acetaminophen May Be Fueling Antibiotic Resistance
NEW DELHI-- Widely used painkillers like ibuprofen and acetaminophen may be quietly accelerating one of the world’s most urgent health crises — antibiotic resistance...
Study Reveals Why Diabetes Fuels More Aggressive Breast Cancers
NEW DELHI-- People with Type 2 obesity-driven diabetes are more likely to develop aggressive forms of breast cancer, and researchers have now uncovered a...